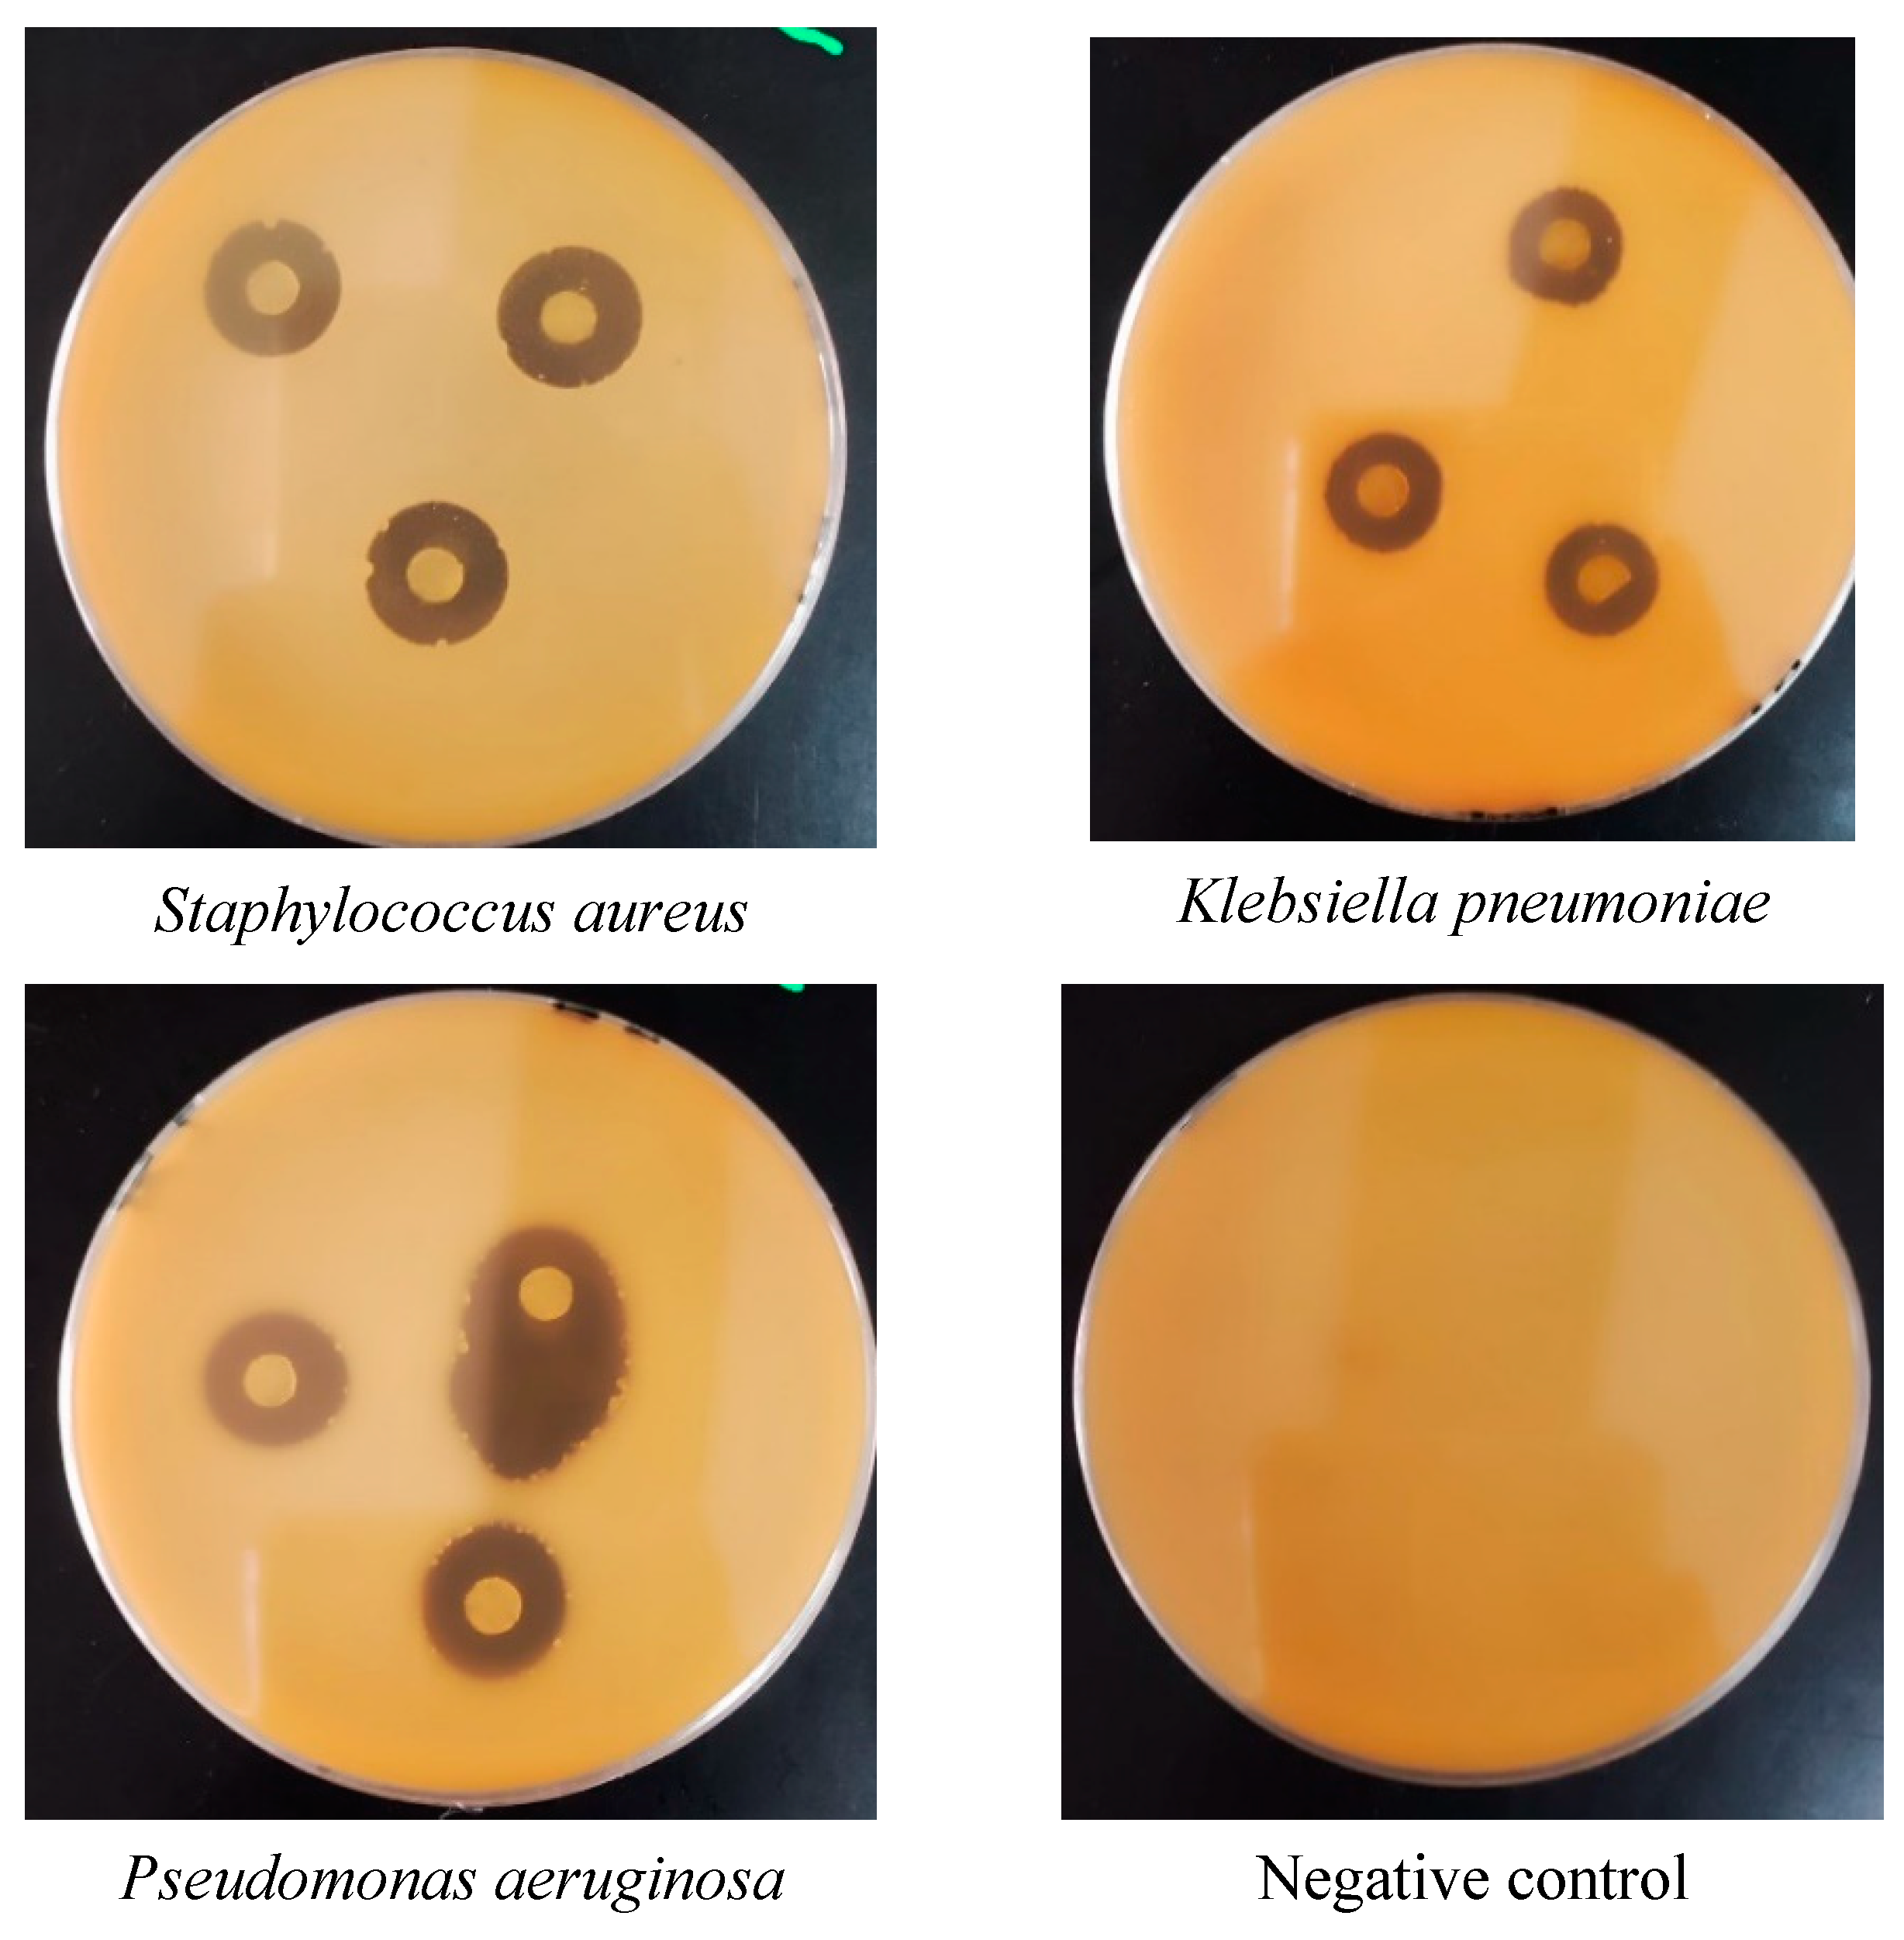
Horticulturae 11 00265 g005

Chemical, Mineralogical, and Biological Properties of Pistacia atlantica subsp. atlantica Essential Oils from the Middle Atlas of Morocco
Abstract
1. Introduction
2. Materials and Methods
2.1. Plant Materials
2.2. Mineralogical Analysis
2.3. Phytochemical Analysis
2.3.1. Preparation of Extracts
2.3.2. Phytochemical Screening
- Tannins—The presence of tannins can be detected by mixing 1 mL of the extract with 1 mL of 1% FeCl3 solution, resulting in a greenish or blackish coloration [12];
- Catechins—Boiling a mixture of 5 mL infusion and 1 mL concentrated hydrochloric acid for 15 min produces a red precipitate that dissolves in amyl alcohol, indicating the presence of catechins [12];
- Gallotannins—After heating a mixture of 30 mL infusion solution and 15 mL Stianini reagent in a water bath for 15 min, the precipitate is filtered off and the filtrate is saturated with 5 g sodium acetate powder. We then add 1 mL of 1× Cl3 solution dropwise. The formation of a precipitate indicates the presence of gallotannins [12];
- Flavonoids—Add 1 mL infusion to 1 mL hydrochloric alcohol, then add magnesium chips and 1 mL isoamyl alcohol. A pink-orange (flavones), purple-pink (flavonone) or reddish (flavanol, flavanol) color appears in the isoamyl alcohol layer of the supernatant, indicating the presence of free flavonoids (genin) [12];
- Saponins—The presence of saponins is determined by vigorously shaking a mixture of 0.2 mL extract and 5 mL distilled water for 5 min. The persistence of foam after shaking indicates the presence of saponins [13];
- Sterols (Shalkowski test)—To identify sterols, 1 mL H2SO4 is added to the extract. The formation of a reddish-brown ring at the interface between the two liquids confirms the presence of sterols [14];
- Alkaloids—Two manipulations were carried out to identify [13] alkaloids.
- Manipulation 1: For the Dragendorff test, a mixture of 1 mL extract and 1 mL Dragendorff reagent was prepared. The formation of an orange cloud indicates the presence of alkaloids.
- Manipulation 2: In the Meyer test, a mixture of 1 mL extract and 1 mL Meyer’s reagent was prepared. The presence of alkaloids is indicated by a yellow color;
- Cardiac glycosides—The presence of cardiac glycosides was determined by mixing 2 mL of chloroform with 1 mL of the extract. The addition of H2SO4 resulted in the formation of a reddish-brown color, indicating the presence of cardiac glycosides [15];
- Oses and holosides—To detect the presence of oses and holosides, 1 mL of the extract was added to 2–3 drops of concentrated sulfuric acid. After 5 min, 3–4 drops of saturated thymol alcohol were added, producing a red coloration [16];
- Mucilage—Mucilage was detected by combining 1 mL of the extract with 5 mL of pure alcohol. The appearance of granular sediment confirmed the presence of mucilage [16].
2.3.3. Gas Chromatography Coupled with Mass Spectrometry (GC/MS)
2.3.4. Study of Antioxidant Activity
- DPPH free radical scavenging test
- Ferric antioxidant reducing power test (FRAP)
- Docking studies
2.4. Assessment of the Essential Oil Antimicrobial Properties
2.4.1. Disc Broad Casting Method
2.4.2. Liquid Microdilution Method
3. Results and Discussion
3.1. Mineralogical Analysis
3.2. Phytochemical Screening
3.3. Phytochemical Analysis by GC-MS
3.4. Antioxidant Activity of EOPA in the Three Zones
3.5. Docking Studies
3.6. Assessment of the Oil’s Antimicrobial Properties
3.6.1. Agar Diffusion Method
3.6.2. Disc Distribution Method
4. Conclusions
Author Contributions
Funding
Data Availability Statement
Acknowledgments
Conflicts of Interest
References
- Marengo, J.A.; Souza, C.M.; Thonicke, K.; Burton, C.; Halladay, K.; Betts, R.A.; Alves, L.M.; Soares, W.R. Changes in Climate and Land Use Over the Amazon Region: Current and Future Variability and Trends. Front. Earth Sci. 2018, 6, 228. [Google Scholar] [CrossRef]
- Monjauze, A. Connaissance du bétoum Pistacia atlantica Desf. Rev. For. Française 1980, 32, 356–363. [Google Scholar] [CrossRef]
- Bellakhdar, J. Contribution à l’étude de La Pharmacopée Traditionnelle Au Maroc: La Situation Actuelle, Les Produits, Les Sources Du Savoir (Enquête Ethnopharmacologique de Terrain Réalisée de 1969 à 1992). Ph.D. Thesis, Université Paul Verlaine-Metz, Metz, France, 1997. [Google Scholar]
- Bassouya, M.; Chedadi, M.; Zahra, J.F.; Kara, M.; Assouguem, A.; Ullah, R.; Ibrahim, M.A.; Bari, A.; Fidan, H.; Soufyane, L.; et al. A Comparative Analysis of Dendrometric, Macromorphological, and Micromorphological Characteristics of Pistacia atlantica subsp. atlantica and Pistacia terebinthus in the Middle Atlas Region of Morocco. Open Life Sci. 2024, 19, 20220941. [Google Scholar] [CrossRef] [PubMed]
- Zohary, M. Vegetation of the Near Eastern Deserts: I—Environment and Vegetation Classes. Isr. Explor. J. 1952, 2, 201–215. [Google Scholar]
- Bassouya, M.; Jawhari, F.Z.; Lafraxo, S.; Chedadi, M.; Bari, A. Study of the Effect of Pretreatments on the Germination and Growth of Pistacia atlantica subsp. atlantica: Investigations for the Conservation of an Endangered Species in Morocco. BIO Web Conf. 2024, 115, 06001. [Google Scholar] [CrossRef]
- Ballero, M.; Poli, F.; Sacchetti, G.; Loi, M.C. Ethnobotanical Research in the Territory of Fluminimaggiore (South-Western Sardinia). Fitoterapia 2001, 72, 788–801. [Google Scholar] [CrossRef]
- Maxia, A.; Lancioni, M.C.; Balia, A.N.; Alborghetti, R.; Pieroni, A.; Loi, M.C. Medical Ethnobotany of the Tabarkins, a Northern Italian (Ligurian) Minority in South-Western Sardinia. Genet. Resour. Crop Evol. 2008, 55, 911–924. [Google Scholar] [CrossRef]
- Aissi, O.; Boussaid, M.; Messaoud, C. Essential Oil Composition in Natural Populations of Pistacia lentiscus L. from Tunisia: Effect of Ecological Factors and Incidence on Antioxidant and Antiacetylcholinesterase Activities. Ind. Crops Prod. 2016, 91, 56–65. [Google Scholar] [CrossRef]
- Bozorgi, M.; Memariani, Z.; Mobli, M.; Salehi Surmaghi, M.H.; Shams-Ardekani, M.R.; Rahimi, R. Five Pistacia Species (P. vera, P. atlantica, P. terebinthus, P. khinjuk, and P. lentiscus): A Review of Their Traditional Uses, Phytochemistry, and Pharmacology. Sci. World J. 2013, 2013, 219815. [Google Scholar] [CrossRef]
- Hajaji, H.E.; Farah, A.; Ennabili, A.; Bousta, D.; Greche, H.; Bali, B.E.; Lachkar, M. Etude comparative de la composition minérale des constituants de trois catégories de Ceratonia siliqua L. (Comparative study of the mineral composition of the constituents of three varieties of Ceratonia siliqua L.). J. Mater. Environ. Sci. 2013, 4, 165–170. [Google Scholar]
- Judith, M.D. Étude Phytochimique et Pharmacologique de Cassia Nigricans Vhal (Caeslpiniaceae) Utilisée Dans Le Traitement Des Dermatoses Au Tchad. Ph.D. Thesis, Université de Bamako, Bamako, Mali, 2005. [Google Scholar]
- Dohou, N.; Yamni, K.; Tahrouch, S.; Hassani, L.M.I.; Badoc, A.; Gmira, N. Screening phytochimique d’une endémique ibéro-marocaine. Bull.-Société Pharm. Bordx. 2003, 142, 61–78. [Google Scholar]
- Nene Bi, S.; Traore, F.; Zahoui, O.; Soro, T. Composition chimique d’un extrait aqueux de bridelia ferruginea benth. (euphorbiaceae) et études de ses effets toxicologique et pharmacologique chez les mammifères. Afr. Sci. Rev. Int. Des. Sci. Technol. 2010, 4, 287–305. [Google Scholar] [CrossRef]
- Yam, M.F.; Ang, L.F.; Salman, I.M.; Ameer, O.Z.; Lim, V.; Ong, L.M.; Ahmad, M.; Asmawi, M.Z.; Basir, R. Orthosiphon stamineus Leaf Extract Protects Against Ethanol-Induced Gastropathy in Rats. J. Med. Food 2009, 12, 1089–1097. [Google Scholar] [CrossRef] [PubMed]
- Diallo, A. Etude de La Phytochimie et Des Activités Biologiques de Syzygium guineense Willd. (Myrtaceae). Ph.D. Thesis, University of Bamako, Bamako, Mali, 2005; pp. 38–47. [Google Scholar]
- Adams, R.P. Identification of Essential Oil Components by Gas Chromatography/Mass Spectrometry, 5th ed.; Texensis Publishing: Gruver, TX, USA, 2017. [Google Scholar]
- Tepe, B.; Daferera, D.; Sokmen, A.; Sokmen, M.; Polissiou, M. Antimicrobial and Antioxidant Activities of the Essential Oil and Various Extracts of Salvia tomentosa Miller (Lamiaceae). Food Chem. 2005, 90, 333–340. [Google Scholar] [CrossRef]
- Oyaizu, K.; Choi, W.; Nishide, H. Functionalization of Poly(4-chloromethylstyrene) with Anthraquinone Pendants for Organic Anode-active Materials. Polym. Adv. Technol. 2011, 22, 1242–1247. [Google Scholar] [CrossRef]
- El Fadili, M.; Er-rajy, M.; Mujwar, S.; Ajala, A.; Bouzammit, R.; Kara, M.; Abuelizz, H.A.; Er-rahmani, S.; Elhallaoui, M. In Silico Insights into the Design of Novel NR2B-Selective NMDA Receptor Antagonists: QSAR Modeling, ADME-Toxicity Predictions, Molecular Docking, and Molecular Dynamics Investigations. BMC Chem. 2024, 18, 142. [Google Scholar] [CrossRef]
- El Fadili, M.; Er-Rajy, M.; Kara, M.; Assouguem, A.; Belhassan, A.; Alotaibi, A.; Mrabti, N.N.; Fidan, H.; Ullah, R.; Ercisli, S.; et al. QSAR, ADMET In Silico Pharmacokinetics, Molecular Docking and Molecular Dynamics Studies of Novel Bicyclo (Aryl Methyl) Benzamides as Potent GlyT1 Inhibitors for the Treatment of Schizophrenia. Pharmaceuticals 2022, 15, 670. [Google Scholar] [CrossRef]
- Bouzammit, R.; Belchkar, S.; El Fadili, M.; Kanzouai, Y.; Aflak, N.; Chalkha, M.; Bahsis, L.; Nakkabi, A.; Bakhouch, M.; Gal, E.; et al. Synthesis, Characterization, DFT Mechanistic Study, Antibacterial Activity, Molecular Modeling, and ADMET Properties of Novel Chromone-Isoxazole Hybrids. J. Mol. Struct. 2024, 1314, 138770. [Google Scholar] [CrossRef]
- Ed-Dahmani, I.; El Fadili, M.; Kandsi, F.; Conte, R.; El Atki, Y.; Kara, M.; Assouguem, A.; Touijer, H.; Lfitat, A.; Nouioura, G.; et al. Phytochemical, Antioxidant Activity, and Toxicity of Wild Medicinal Plant of Melitotus albus Extracts, In Vitro and In Silico Approaches. ACS Omega 2024, 9, 9236–9246. [Google Scholar] [CrossRef]
- Nouioura, G.; El Fadili, M.; El Barnossi, A.; Loukili, E.H.; Laaroussi, H.; Bouhrim, M.; Giesy, J.P.; Aboul-Soud, M.A.M.; Al-Sheikh, Y.A.; Lyoussi, B.; et al. Comprehensive Analysis of Different Solvent Extracts of Ferula communis L. Fruit Reveals Phenolic Compounds and Their Biological Properties via In Vitro and In Silico Assays. Sci. Rep. 2024, 14, 8325. [Google Scholar] [CrossRef]
- Nouioura, G.; El Fadili, M.; El Hachlafi, N.; Maache, S.; Mssillou, I.; Abuelizz, A.H.; Lafdil, F.Z.; Er-rahmani, S.; Lyoussi, B.; Derwich, E. Coriandrum sativum L., Essential Oil as a Promising Source of Bioactive Compounds with GC/MS, Antioxidant, Antimicrobial Activities: In Vitro and in Silico Predictions. Front. Chem. 2024, 12, 1369745. [Google Scholar] [CrossRef] [PubMed]
- Zouirech, O.; Alyousef, A.A.; El Barnossi, A.; El Moussaoui, A.; Bourhia, M.; Salamatullah, A.M.; Ouahmane, L.; Giesy, J.P.; Aboul-soud, M.A.M.; Lyoussi, B.; et al. Phytochemical Analysis and Antioxidant, Antibacterial, and Antifungal Effects of Essential Oil of Black Caraway (Nigella sativa L.) Seeds against Drug-Resistant Clinically Pathogenic Microorganisms. BioMed Res. Int. 2022, 2022, 5218950. [Google Scholar] [CrossRef] [PubMed]
- El Barnossi, A.; Moussaid, F.; Housseini, A.I. Antifungal Activity of Bacillussp. Gn-A11-18isolated from Decomposing Solid Green Household Waste in Water and Soil against Candida albicans and Aspergillus niger. In E3S Web of Conferences; EDP Sciences: Les Ulis, France, 2020; Volume 150, p. 02003. [Google Scholar]
- Goncalves, R.; Ayres, V.F.; Carvalho, C.E.; Souza, M.G.; Guimaraes, A.C.; Correa, G.M.; Martins, C.H.; Takeara, R.; Silva, E.O.; Crotti, A.E. Chemical Composition and Antibacterial Activity of the Essential Oil of Vitex agnus-castus L. (Lamiaceae). An. Acad. Bras. Ciências 2017, 89, 2825–2832. [Google Scholar] [CrossRef] [PubMed]
- Huskisson, E.; Maggini, S.; Ruf, M. The Role of Vitamins and Minerals in Energy Metabolism and Well-Being. J. Int. Med. Res. 2007, 35, 277–289. [Google Scholar] [CrossRef]
- Abidine, A.Z.E.; Bouderrah, M.; Lamhamedi, M.S.; Mounir, F.; Jean, V.H.-M.S.; Ponette, Q. Choix Des Essences de Reboisement Pour La Forêt de La Maâmora (Maroc) Sur La Base de La Tolérance Des Plants Juvéniles à La Sécheresse. Physio-Géo. Géographie Phys. Environ. 2020, 15, 133–160. [Google Scholar] [CrossRef]
- Siahnouri, Z.; Sadeghian, M.; Salehisormghi, M.; Qomi, M. Determination of Iranian Walnut and Pistachio Mineral Contents. J. Basic Appl. Sci. Res. 2013, 3, 217–220. [Google Scholar]
- Boudieb, K. Valorisation et Caractérisations Physicochimique et Phytochimique Du Pistachier Lentisque (Pistacia lentiscus L.) d’Algérie et l’incorporation de La Poudre Des Fruits Dans Une Préparation Laitière. Ph.D. Thesis, Département Bio, Université de Boumerdès-M’hamed Bougara, Boumerdes, Algeria, 2020. [Google Scholar]
- Ben Ahmed, Z.; Yousfi, M.; Viaene, J.; Dejaegher, B.; Demeyer, K.; Heyden, Y.V. Quatre Sous-Espèces de Pistacia atlantica (Atlantica, Cabulica, Kurdica et Mutica): Un Aperçu de Leur Botanique, Ethnobotanique, Phytochimie et Pharmacologie. J. Ethnopharmacol. 2021, 265, 113329. [Google Scholar] [CrossRef]
- Ahmed, Z.B.; Yousfi, M.; Viaene, J.; Dejaegher, B.; Demeyer, K.; Vander Heyden, Y. Four Pistacia atlantica Subspecies (Atlantica, Cabulica, Kurdica and Mutica): A Review of Their Botany, Ethnobotany, Phytochemistry and Pharmacology. J. Ethnopharmacol. 2021, 265, 113329. [Google Scholar] [CrossRef]
- Elmakaoui, A.; Damour, H.; Bourais, I.; Badaoui, B.; Imtara, H.; Oubihi, A.; Noman, M.; Tarayrah, M. Chemical Composition, Antioxidant Potential and Antibacterial Activity of Pistacia atlantica Desf. Essential Oil Leaves, with a Focus on Variations in the Main Trunk Diameter; Records of Natural Products: Kocaeli, Türkiye, 2024. [Google Scholar]
- Dalvand, H.; Hamdi, S.M.M.; Kotanaee, F.N.; Ahmadvand, H. Phytochemicals Analysis and Antioxidant Potential of Hydroalcoholic Extracts of Fresh Fruits of Pistacia atlantica and Pistacia khinjuk. Plant Sci. Today 2024, 11, 513–520. [Google Scholar] [CrossRef]
- Said, S.A.; Fernandez, C.; Greff, S.; Derridj, A.; Gauquelin, T.; Mevy, J.-P. Inter-Population Variability of Leaf Morpho-Anatomical and Terpenoid Patterns of Pistacia atlantica Desf. ssp. Atlantica Growing along an Aridity Gradient in Algeria. Flora-Morphol. Distrib. Funct. Ecol. Plants 2011, 206, 397–405. [Google Scholar] [CrossRef]
- Peksel, A. Antioxidative Properties of Decoction of Pistacia atlantica Desf. Leaves. Asian J. Chem. 2008, 20, 681–693. [Google Scholar]
- Farhoosh, R.; Tavassoli-Kafrani, M.H.; Sharif, A. Antioxidant Activity of the Fractions Separated from the Unsaponifiable Matter of Bene Hull Oil. Food Chem. 2011, 126, 583–589. [Google Scholar] [CrossRef]
- Farhoosh, R.; Tavassoli-Kafrani, M.H.; Sharif, A. Antioxidant Activity of Sesame, Rice Bran and Bene Hull Oils and Their Unsaponifiable Matters. Eur. J. Lipid Sci. Technol. 2011, 113, 506–512. [Google Scholar] [CrossRef]
- Gourine, N.; Yousfi, M.; Bombarda, I.; Nadjemi, B.; Stocker, P.; Gaydou, E.M. Antioxidant Activities and Chemical Composition of Essential Oil of Pistacia atlantica from Algeria. Ind. Crops Prod. 2010, 31, 203–208. [Google Scholar] [CrossRef]
- Orhan, I.E.; Senol, F.S.; Gulpinar, A.R.; Sekeroglu, N.; Kartal, M.; Sener, B. Neuroprotective Potential of Some Terebinth Coffee Brands and the Unprocessed Fruits of Pistacia terebinthus L. and Their Fatty and Essential Oil Analyses. Food Chem. 2012, 130, 882–888. [Google Scholar] [CrossRef]
- Rezaie, M.; Farhoosh, R.; Iranshahi, M.; Sharif, A.; Golmohamadzadeh, S. Extraction Assistée Par Ultrasons de Composés Antioxydants de La Coque de Pistacia atlantica subsp. Mutica à l’aide de Divers Solvants de Différentes Propriétés Physicochimiques. Food Chem. 2015, 173, 577–583. [Google Scholar] [CrossRef]
- Labed-Zouad, I.; Ferhat, M.; Öztürk, M.; Abaza, I.; Nadeem, S.; Kabouche, A.; Kabouche, Z. Essential Oils Composition, Anticholinesterase and Antioxidant Activities of Pistacia atlantica Desf. Rec. Nat. Prod. 2017, 11, 411–415. [Google Scholar]
- da Costa Vieira, G.H.; Barbosa-Dias, B.; Ozório-Leonel, D.C. Essential Oils: Properties, Applications, Extraction Methods, and Perspectives; Nova Science Publishers, Inc.: New York, NY, USA, 2016; Volume 1, pp. 1–18. [Google Scholar]
- Mecherara-Idjeri, S.; Hassani, A.; Castola, V.; Casanova, J. Composition of Leaf, Fruit and Gall Essential Oils of Algerian Pistacia atlantica Desf. J. Essent. Oil Res. 2008, 20, 215–219. [Google Scholar] [CrossRef]
- Bruneton, J. Pharmacognosie, Phytochimie, Plantes Médicinales, 4th ed.; Lavoisier: Paris, France, 2009; Volume 4, pp. 245–246. [Google Scholar]
- Egwaikhide, P.A.; Bulus, T.; Emua, S.A. Antimicrobial Activities and Phytochemical Screening of Extracts of the Fever Tree, Eucalyptus Globulus. |EBSCOhost. Available online: https://openurl.ebsco.com/contentitem/gcd:55729803?sid=ebsco:plink:crawler&id=ebsco:gcd:55729803 (accessed on 22 December 2024).
- Benabderrahmane, M.; Benali, M.; Aouissat, H.; Bueso, M.-J.J. Activité antimicrobienne des huiles essentielles de Pistacia atlantica Desf. de l’Algérie. Phytothérapie 2009, 7, 304–308. [Google Scholar] [CrossRef]
- Kamrani, Y.Y.; Amanlou, M.; Esmaeelian, B.; Rahimi, M. In vitro antibacterial and antiadherence properties of flavonoid-rich extract of Pistacia atlantica hull against microorganisms involved in dental plaque. Planta Med. 2007, 73, 198. [Google Scholar] [CrossRef]
- Othman, S.O.K.; El-Hashash, M.A.; Hussein, S.; El-Mesallamy, A.M.D.; Rizk, S.A.; Elabbar, F.A. Phenolic Content as Antioxidant and Antimicrobial Activities of Pistacia atlantica Desf. (Anacardiaceae) Extract from Libya. Egypt. J. Chem. 2019, 62, 21–28. [Google Scholar] [CrossRef]
- Inouye, S.; Takizawa, T.; Yamaguchi, H. Antibacterial Activity of Essential Oils and Their Major Constituents against Respiratory Tract Pathogens by Gaseous Contact. J. Antimicrob. Chemother. 2001, 47, 565–573. [Google Scholar] [CrossRef] [PubMed]
- Sikkema, J.; De Bont, J.A.; Poolman, B. Mechanisms of Membrane Toxicity of Hydrocarbons. Microbiol. Rev. 1995, 59, 201–222. [Google Scholar] [CrossRef] [PubMed]

| Staphylococcus aureus | ATCC 6633 |
| Escherichia coli | K12 |
| Bacillus subtilis | DSM 6333 |
| Klebsiella pneumoniae | CIP A22 |
| Pseudomonas aeruginosa | CIP 82.114 |
| Candida albicans | ATCC 10231 |
| Ca | Cu | Fe | K | Mg | Mn | Na | P | Pb | Se | Zn | |
|---|---|---|---|---|---|---|---|---|---|---|---|
| LPA1 | 2005.56 | 0.42 | 39.02 | 1164.96 | 553.37 | 2.85 | 55.13 | 144.76 | 0.17 | <0.02 | 1.68 |
| LPA2 | >2250.00 | 0.53 | 34.80 | 1229.51 | 559.60 | 3.64 | 160.23 | 102.69 | <0.02 | <0.02 | 1.78 |
| LPA3 | >2250.00 | 0.49 | 31.67 | 1001.01 | 356.72 | 1.90 | 147.22 | 96.98 | 0.22 | <0.02 | 1.40 |
| Secondary Metabolites | Extract of PA | |
|---|---|---|
| Tannins | + | |
| Tannins | T. Catechicals | − |
| T. Gallics | + | |
| Flavonoids | +++ | |
| Saponosides | ++ | |
| Sterols and terpenes | +++ | |
| Alkaloids | − | |
| Cardiac glycosides | ++ | |
| Oses and holosides | ++ | |
| Mucilage | ++ | |
| R.T (min) | Compounds | R.I | Chemical Class | Area (%) | |||
|---|---|---|---|---|---|---|---|
| Cal | Lit | EOPAA1 | EOPAA2 | EOPAA3 | |||
| 7.59 | Tricyclene | 924 | 926 | MO.H | - | - | 0.4 |
| 7.67 | α-Thujene | 930 | 930 | MO.H | - | 0.4 | - |
| 7.90 | α-Pinene | 932 | 933 | MO.H | - | 6.5 | 9.9 |
| 8.37 | Camphene | 945 | 949 | MO.H | - | 1.6 | 1.9 |
| 9.03 | Sabinene | 971 | 975 | MO.H | - | 6.4 | 0.5 |
| 9.18 | β-Pinene | 977 | 980 | MO.H | - | 1.3 | 3.6 |
| 9.48 | Myrcene | 987 | 990 | MO.H | - | 1.1 | 1.5 |
| 10.00 | α-Phellandrene | 1000 | 1002 | MO.H | - | - | 0.4 |
| 10.32 | α-Terpinene | 1015 | 1018 | MO.H | - | 0.8 | - |
| 10.55 | o-Cymene | 1024 | 1026 | MO.H | - | 4.9 | 3.4 |
| 10.70 | D-Limonene | 1028 | 1029 | MO.H | - | 1.6 | 8.7 |
| 10.79 | Eucalyptol | 1030 | 1031 | MO.O | - | 6.9 | - |
| 11.57 | γ-Terpinene | 1055 | 1059 | MO.H | - | 1.9 | - |
| 12.39 | Terpinolene | 1085 | 1088 | MO.H | - | 0.8 | 0.8 |
| 14.05 | Pinocarveol | 1135 | 1139 | MO.O | - | - | 1.0 |
| 14.22 | Norbornen-2-ol acetate | 1085 | 1090 | O | - | 1.1 | - |
| 14.96 | Borneol | 1165 | 1169 | MO.O | - | 1.2 | - |
| 15.21 | p-Menth-2-en-1-ol | 1120 | 1121 | MO.O | - | - | 1.3 |
| 15.28 | Terpinen-4-ol | 1175 | 1177 | MO.O | 7.9 | - | - |
| 15.36 | p-Cymen-7-ol | 1287 | 1290 | MO.O | - | - | 0.7 |
| 15.60 | endo-Fenchol | 1285 | 1288 | MO.O | - | - | 2.5 |
| 15.63 | Fenchone | 1084 | 1086 | MO.O | - | 2.2 | - |
| 15.69 | Terpineol | 1196 | 1199 | MO.O | 0.9 | 8.1 | - |
| 18.15 | Bornyl acetate | 1285 | 1288 | O | - | 1.4 | 1.4 |
| 19.09 | 1.4-cineole | 1011 | 1014 | MO.O | - | - | 0.7 |
| 19.13 | Anethole | 1250 | 1252 | MO.O | - | 0.9 | - |
| 19.58 | Elemene | 1333 | 1335 | ST.H | 1.7 | 1.4 | - |
| 19.81 | α-Terpinyl acetate | 1313 | 1317 | O | - | 0.4 | - |
| 19.89 | α-Cubebene | 1345 | 1348 | ST.H | - | - | 0.4 |
| 20.51 | Ylangene | 1420 | 1420 | ST.H | - | - | 0.4 |
| 20.67 | α-Copaene | 1370 | 1374 | ST.H | - | - | 1.0 |
| 20.89 | β-Bourbonene | 1385 | 1388 | ST.H | - | - | 0.4 |
| 21.00 | β-Elemene | 1588 | 1589 | ST.H | - | 0.5 | - |
| 21.10 | α-Gurjunene | 1407 | 1409 | ST.H | - | - | 1.2 |
| 21.92 | Caryophyllene | 1462 | 1464 | ST.H | 7.8 | 1.6 | 3.8 |
| 22.12 | Germacrene B | 1560 | 1561 | ST.H | 0.9 | 1.4 | 0.8 |
| 22.17 | β-Copaene | 1430 | 1432 | ST.H | 1.5 | 0.7 | 0.6 |
| 22.20 | Phenol acetate | 1440 | 1442 | MO.O | - | 0.4 | - |
| 22.23 | β-Ionone | 1432 | 1436 | O | - | - | 0.5 |
| 22.31 | Aromandendrene | 1440 | 1441 | ST.H | - | 0.6 | 0.7 |
| 22.62 | Cadalene | 1674 | 1676 | ST.H | - | 0.7 | - |
| 22.71 | Maaliol | 1566 | 1567 | ST.O | 1.0 | - | - |
| 22.73 | α-Humulene | 1450 | 1454 | ST.H | - | - | 2.1 |
| 22.85 | Indole | 1290 | 1291 | O | - | 0.6 | - |
| 22.96 | Isolongifolene | 1388 | 1390 | ST.H | 1.0 | - | - |
| 23.29 | γ-Cadinene | 1510 | 1513 | ST.H | 2.3 | 0.6 | 2.8 |
| 23.30 | α-Amorphene | 1484 | 1484 | ST.H | - | - | 0.7 |
| 23.46 | Germacrene D | 1486 | 1485 | ST.H | 26.5 | 10.2 | 5.0 |
| 23.63 | γ-Muurolene | 1477 | 1479 | ST.H | - | - | 2.2 |
| 23.72 | Viridiflorine | 1495 | 1496 | ST.H | 2.2 | 1.2 | - |
| 23.83 | Bicyclogermacrene | 1730 | 1734 | ST.H | 6.6 | 3.5 | - |
| 23.86 | Verbenone | 1206 | 1205 | MO.O | - | - | 1.1 |
| 24.24 | α-Cadinene | 1537 | 1538 | ST.H | 1.3 | 0.9 | 3.4 |
| 24.26 | Cadinene ether | 1550 | 1553 | ST.O | - | - | 6.1 |
| 24.33 | cis-Calamenene | 1710 | 1713 | ST.O | - | - | 1.3 |
| 24.36 | δ-Cadinene | 1801 | 1803 | ST.H | 5.3 | 2.0 | - |
| 24.85 | Cadalene | 1675 | 1676 | ST.H | - | - | 0.8 |
| 25.01 | Elemol | 1546 | 1549 | ST.O | - | 0.4 | 0.5 |
| 25.21 | Germacra-4(15),5,10(14)-trien-1α-ol | 1684 | 1686 | ST.O | - | - | 4.7 |
| 25.75 | Hexenyl benzoate | 1563 | 1566 | O | 1.7 | - | - |
| 26.01 | Spathulenol | 1575 | 1578 | ST.O | 15.6 | 5.5 | 3.8 |
| 26.06 | Alloaromadendrene oxide | 1640 | 1641 | ST.H | - | 0.9 | 0.6 |
| 26.29 | Globulol | 1588 | 1590 | ST.O | 2.1 | 1.6 | 0.7 |
| 26.55 | Viridiflorol | 1590 | 1592 | ST.O | 1.4 | 1.7 | - |
| 27.13 | Caryophyllene oxide | 1580 | 1583 | ST.O | 1.4 | - | - |
| 27.38 | Junenol | 1617 | 1619 | ST.O | 1.1 | - | - |
| 27.50 | γ-Himachalene | 1480 | 1482 | ST.H | - | 1.0 | - |
| 27.93 | α-Muurolol | 1642 | 1646 | ST.O | 7.9 | 4.2 | 5.9 |
| 28.00 | α-Cadinol | 1650 | 1654 | ST.O | 0.8 | - | 0.8 |
| 28.23 | α-muurolene | 1766 | 1768 | ST.H | - | - | 1.0 |
| 29.21 | Eudesma-4,11-dien-2-ol | 1807 | 1808 | ST.O | 1.0 | - | 1.2 |
| 32.44 | Catechol | 1255 | 1258 | O | - | 0.6 | 1.0 |
| 32.75 | Isophytol | 1944 | 1947 | DT.O | - | - | 2.1 |
| 33.28 | Dehydro aromadendrane | 1460 | 1462 | ST.H | - | 0.8 | 1.4 |
| 38.32 | Phytol | 1940 | 1943 | DT.O | - | 0.5 | 1.4 |
| Chemical class | |||||||
| Monoterpene hydrocarbon (MO.H) | 0 | 34.2 | 31.1 | ||||
| Monoterpene oxygenated (MO.O) | 8.8 | 19.7 | 7.3 | ||||
| Sesquiterpene hydrocarbon (ST.H) | 57.1 | 28 | 29.3 | ||||
| Sesquiterpene oxygenated (ST.O) | 32.3 | 13.4 | 25 | ||||
| Diterpene hydrocarbon (DT.H) | 0 | 0 | 0 | ||||
| Diterpene oxygenated (DT.O) | 0 | 0.5 | 3.5 | ||||
| Others (O) | 1.7 | 4.1 | 2.9 | ||||
| Total (%) | 99.9 | 99.9 | 99.1 | ||||
| Artificial Antioxidant | IC50 (mg/mL) | EC50 (mg/mL) |
|---|---|---|
| BHT | 0.009 ± 0.0001 | 1.165 ± 0.114 |
| Ascorbicacid | 0.001 ± 0.001 | 0.003 ± 0.001 |
| IC50 (mg/mL) | |||
|---|---|---|---|
| Sample | Max | Min | Mean ± SD |
| EOPAA1 | 0.431 | 0.394 | 0.414 ± 0.010 |
| EOPAA2 | 0.945 | 0.915 | 0.931 ± 0.008 |
| EOPAA3 | 1.532 | 1.498 | 1.520 ± 0.011 |
| EC50 (mg/mL) | |||
|---|---|---|---|
| Area | Max | Min | Mean ± SD |
| EOPAA1 | 2.183 | 2.09 | 2.132 ± 0.034 |
| EOPAA2 | 5.18 | 4.6 | 4.895 ± 0.195 |
| EOPAA3 | 5.81 | 4.98 | 5.4 ± 0.277 |
Disclaimer/Publisher’s Note: The statements, opinions and data contained in all publications are solely those of the individual author(s) and contributor(s) and not of MDPI and/or the editor(s). MDPI and/or the editor(s) disclaim responsibility for any injury to people or property resulting from any ideas, methods, instructions or products referred to in the content. |
© 2025 by the authors. Licensee MDPI, Basel, Switzerland. This article is an open access article distributed under the terms and conditions of the Creative Commons Attribution (CC BY) license (https://creativecommons.org/licenses/by/4.0/).
Share and Cite
Bassouya, M.; Chedadi, M.; El fadili, M.; Zahra, J.F.; El-byari, Y.; Shahat, A.A.; Morya, S.; El Moussaoui, A.; Kara, M.; Bari, A. Chemical, Mineralogical, and Biological Properties of Pistacia atlantica subsp. atlantica Essential Oils from the Middle Atlas of Morocco. Horticulturae 2025, 11, 265. https://doi.org/10.3390/horticulturae11030265
Bassouya M, Chedadi M, El fadili M, Zahra JF, El-byari Y, Shahat AA, Morya S, El Moussaoui A, Kara M, Bari A. Chemical, Mineralogical, and Biological Properties of Pistacia atlantica subsp. atlantica Essential Oils from the Middle Atlas of Morocco. Horticulturae. 2025; 11(3):265. https://doi.org/10.3390/horticulturae11030265
Chicago/Turabian StyleBassouya, Mohammed, Mohamed Chedadi, Mohamed El fadili, Jawhari Fatima Zahra, Younesse El-byari, Abdelaaty A. Shahat, Sonia Morya, Abdelfattah El Moussaoui, Mohammed Kara, and Amina Bari. 2025. "Chemical, Mineralogical, and Biological Properties of Pistacia atlantica subsp. atlantica Essential Oils from the Middle Atlas of Morocco" Horticulturae 11, no. 3: 265. https://doi.org/10.3390/horticulturae11030265
APA StyleBassouya, M., Chedadi, M., El fadili, M., Zahra, J. F., El-byari, Y., Shahat, A. A., Morya, S., El Moussaoui, A., Kara, M., & Bari, A. (2025). Chemical, Mineralogical, and Biological Properties of Pistacia atlantica subsp. atlantica Essential Oils from the Middle Atlas of Morocco. Horticulturae, 11(3), 265. https://doi.org/10.3390/horticulturae11030265

